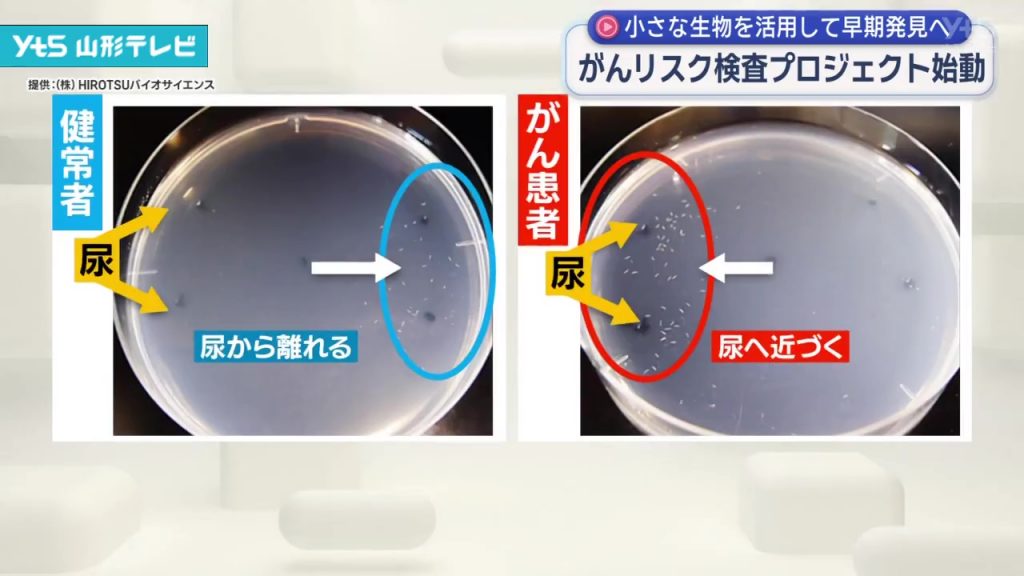

YTS NEWS
News
ホーム開幕戦に向け天童市役所でモンテ応援運動
ホーム開幕を週末に控えたモンテディオ山形を応援しようと、天童市役所でTシャツを着た応援運動が始まりました。
モンテディオのホームスタジアムがある天童市では、毎シーズン、ホーム戦を前に市の職員が応援Tシャツを着て業務にあたっています。職員たちはモンテディオのチームカラーである青を基調にしたTシャツを着ており、中にはサポーターナンバーの12番をつけている人もいます。
通常はホーム戦の3日前から応援Tシャツを着用しますが、今回はホーム開幕戦とあって、期間を5日間に延長しました。
市の職員からは「日々の仕事だけでなく、チームを応援しようという気持ちも一緒に頑張っている」「サポーターとして気分を高める部分もあり、多くの市民の方にも応援に行っていただき、盛り上げていただきたい」といった声が聞かれました。
市役所を訪れた市民は「すごくいいと思う。みんなで盛り上げてもらいたい」「モンテを盛り上げようという気持ちが伝わってきて、選手の皆さんには頑張っていただきたい」と話していました。
ホーム開幕戦は今月8日、秋田と対戦します。
閲覧数ランキング